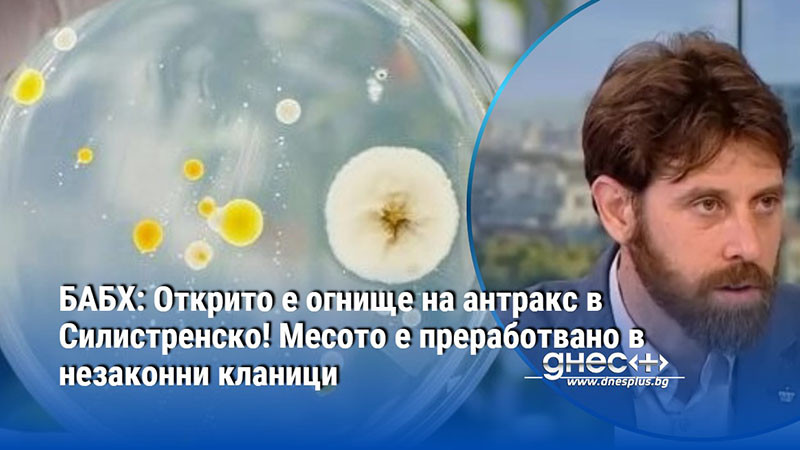
БАБХ: Открито е огнище на антракс в Силистренско! Месото е преработвано в незаконни кланици

България 21.04.2026 11:03 Снимка: ДНЕС+
БАБХ: Открито е огнище на антракс в Силистренско! Месото е преработвано в незаконни кланици
Огнище на антракс беше установено в Силистренско. Животните са лекувани около 30 дни от ветеринарен лекар на обекта, без да бъдат уведомени компетентните власти и без да е била ясна диагнозата.
“Случаят е особено опасен", каза в студиото на “Денят започва” по БНТ д-р Ангел Мавровски - изпълнителен директор на БАБХ.
В момента се издирват всички контактни лица, имали досег със заразените животни. Част от месото е било преработвано, като собствениците твърдят, че е било предназначено за лична консумация. Откритото месо е унищожено.
Д-р Ангел Мавровски - изпълнителен директор на БАБХ: “До момента сме установили 13 души, а РЗИ продължава да установява дали има и други контактни лица. Случаят е особено опасен. Оказва се, че самите животни са преработвани в различни продукти - имам предвид умиращите и умрели животни.”
По данни на изпълнителния директор на БАБХ д-р Ангел Мавровски, месото е преработвано в незаконни кланици.
Д-р Ангел Мавровски - изпълнителен директор на БАБХ: “Имаме и случай на 4 животни, които са взети нелегално от самия обект и са транспортирани към Разградско с цел преработка и продажба. Лицето е установено с полиция.”
Огнището на антракс е лабораторно потвърдено, допълниха от БАБХ.
Още по темата
 CHF
CHF
|
1 | 2.10463 |
 GBP
GBP
|
1 | 2.24498 |
 RON
RON
|
10 | 3.83729 |
 TRY
TRY
|
100 | 3.87564 |
 USD
USD
|
1 | 1.66355 |
Последни новини
- 12:44 МОСВ: Няма опасност за българските води след разлива в руската част на Черно море
- 12:37 Нетаняху ще бъде арестуван, ако влезе в Унгария
- 12:29 Борислав Гуцанов призова лидера на партията Крум Зарков да подаде незабавно оставка
- 12:21 Тръмп: Извличането на иранския уран ще бъде дълъг и сложен процес
- 12:13 Марк Рюте поздрави Румен Радев за изборната победа
- 12:05 Конгресмен в САЩ: Време е Тръмп да се намеси и да каже истината за НЛО и изчезналите учени в САЩ
- 11:57 Петер Мадяр: Нетаняху ще бъде арестуван при посещение в Унгария
- 11:50 Гърция алармира за измамни съобщения, гарантиращи безопасно преминаване през Ормузкия проток













